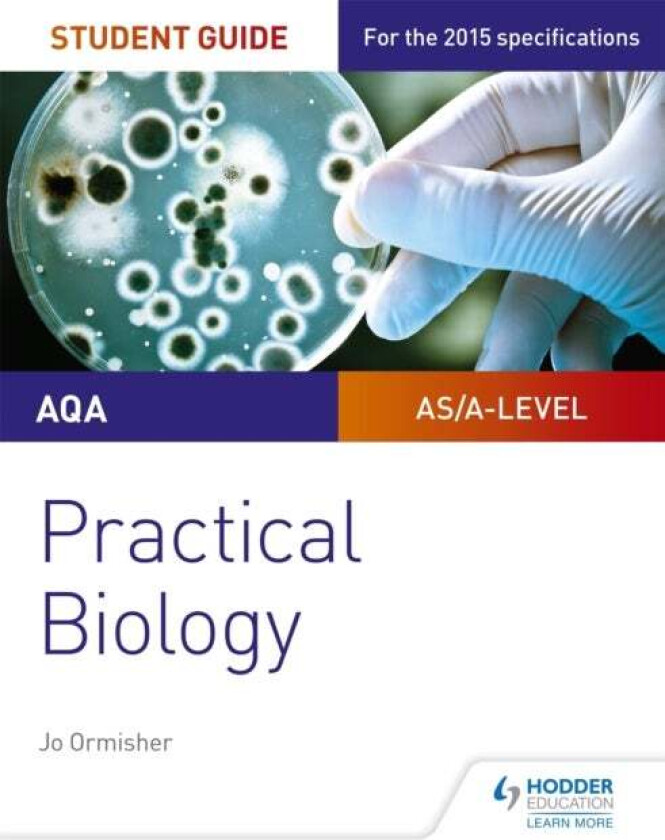
AQA A-level Biology Student Guide: Practical Biology av Jo Ormisher

AQA A-level Biology Student Guide: Practical Biology av Jo Ormisher
Beste pris fra kr 198 og finnes i 3 butikker.
Populære alternativer
Populære merker innen Bøker
Prishistorikk
Prisvarsel
Meld deg opp til prisvarsel og få beskjed med en gang prisen synker.
kr
Egenskaper og detaljer
Generelt
Kategori
Fagbøker, Matematikk og naturvitenskap, Biologi
Strekkoder
GTIN
9781471885587










